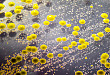

-

-
2021.03.17 顽固性腹水难道真的就只是酒精性肝硬化这么简单吗?
患者,男,69 岁,既往长期饮酒史,因「反复腹胀 1 月余」于 2020-07-31 入院。患者 1 月余前无明显诱因下出现腹胀,伴纳差、乏力,无发热、腹痛等不适,于外...
-

-
2021.03.15 徐珊主任:解读并推广隐睾专家共识,提高疾病诊疗水平
隐睾是常见的先天性泌尿生殖畸形之一,其发病率呈上升趋势,并已成为男性不育的重要原因之一。然而,对于这一疾病,临床上还存在认识不足、诊疗欠规范,治疗方案差异较大的缺憾,而且在治疗时机、手术策略选择、激素
-

-
2021.03.12 80+ 公立医院急招岗位:提供编制,部分不限学历
本周丁香人才汇总了全国26 省市最新招聘岗位,点击医院名称即可查看该院全部在招岗位,还能直接投递,点击地区入口即可查看在招单位。点击医院名称,即可投递☟☟☟◆...
-

-
2021.03.11 一例剧情反转的淋巴结肿大病例
患者,男,46 岁,广西人,因「发现颈部淋巴结肿痛 1 月余」于 2020-06-08 入院。患者 1 月余前无明显诱因下出现颈部淋巴结肿痛,无发热等不适,未重视,后感...
-
-
2021.03.05 血培养表葡怎么打,先打假!
某日有热心网友发来一张血培养报告单(图1),问怎么打,选用什么抗生素。图1 血培养报告单答:临床遇到血培养表葡阳性,先不考虑怎么打,第一步是“打假”:正确解读...
-

-
2021.02.26 发热伴脊柱病变,你知道病因是什么吗?
患者,男,79 岁,因「腰痛 4 月,发热 6 天」于 2017-11-28 入院。患者入院前 4 月无明显诱因下出现腰背部疼痛,伴胸闷气急,
-

-
2021.02.03 远远看别人杀了一次鸭子,怎么就得重症肺炎了呢?
患者,女,52 岁,既往体健,因「乏力 20 余天,发热伴干咳、胸闷 10 余天」于 2021-01-07 入我科
-

-
2021.02.03 2020 年美国 CDC 关于单纯性淋球菌感染治疗指南的更新解读
淋病是由淋病奈瑟菌(Neisseria gonorrhoeae,NG)感染所导致的一种性传播疾病(STD),作为第二常见的细菌性 STD,其严重危害着人类的生殖健康。
-

-
2021.01.12 当带状疱疹病毒遇上艾滋病毒,将会出现什么样的叠加效应?
艾滋病,病原体为人类免疫缺陷病毒(HIV),病毒感染人体后主要侵犯免疫系统,包括 CD4+T 淋巴细胞、单核巨噬细胞和树突状细胞等
-

-
2020.12.31 潜在杀手:HIV 相关隐球菌性脑膜炎
隐球菌病是由隐球菌引起的机会性感染,与获得性免疫缺陷综合征(AIDS)密切相关。隐球菌属包括17个种和18个变种,其中新生隐球菌是本病最主要的病原菌。隐球菌性脑膜炎...
